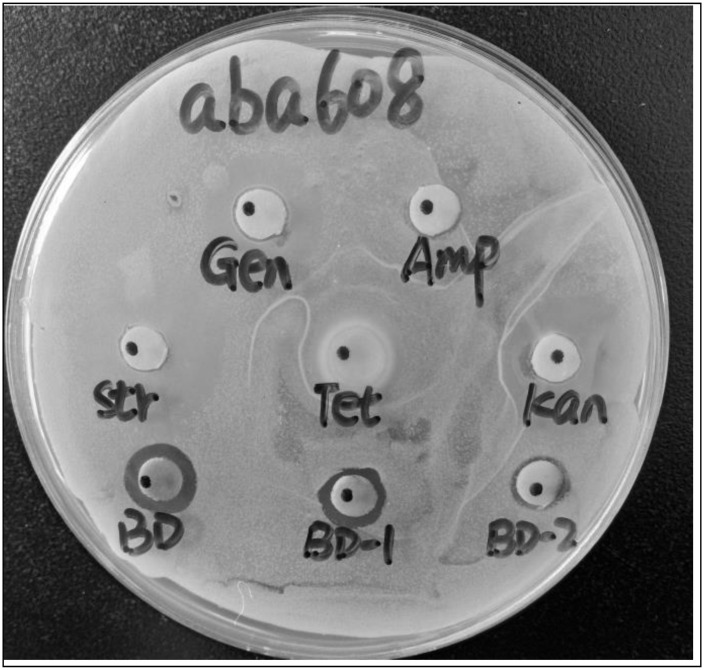
圖 1

牛樟芝抗 ESKAPE 病原體生物活性化合物的分離與鑑定
圖
圖 1. 抗菌活性A ....
圖1. A 的抗菌活性。 樟樹萃取物與 5 種抗生素的比較。
Gen. 代表慶大霉素,...
圖 1. 樟芝萃取物與 5 種抗生素的抗菌活性比較。 Gen. 代表慶大霉素,Amp。代表氨芐西林,Str。代表鏈黴素,Tet。代表四環素,Kan. 代表卡那黴素,BD 代表樟芝萃取物(50.00 mg/mL),BD-1 代表樟芝萃取物(25.00 mg/mL),BD-2 代表樟芝萃取物(12.50 mg /mL) 。
圖 2. A .… 的抗菌活性
圖2. A 的抗菌活性。 樟樹萃取物對抗食源性病原體。
圖2. 樟芝萃取物對食源性病原體的抗菌活性。
圖 3. 化合物 MBBD 對…的 MICBD
圖3. 化合物MBBD 對食源性病原體的MIC。
數值為 n... 的平均值...
圖 3. 化合物 MBBD 對食源性病原體的 MIC。 數值為n = 3 次實驗的平均值。 / >圖 4. 化合物 MBBD 對…的 MIC
圖 4. 化合物 MBBD 對抗藥性病原菌的 MIC。
數據報告為平均值...
圖 4. 化合物 MBBD 對抗藥性病原菌的 MIC。 數據報告為一式三份孔的平均值±SD。數值是 n = 3 次實驗的平均值。
圖5. 化合物的細胞抑制率. ..
圖5.化合物MBBD(40μM)的細胞抑制率。
圖5.化合物MBBD(40μM)的細胞抑制率。
圖 6. 陽性…的細胞抑制率
圖6.陽性對照組DDP和紫杉醇的細胞抑制率。
圖6.陽性對照組DDP和紫杉醇的細胞抑制率。
圖 7. MBBD 和…的化學結構
圖7.MBBD及其類似物的化學結構。
圖7.MBBD及其類似物的化學結構。 所有人物 (7)